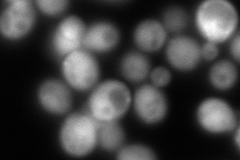
YLR316C

View description
Subunit of tRNA-specific adenosine-34 deaminase, forms a heterodimer with Tad2p that converts adenosine to inosine at the wobble position of several tRNAs
Localization:
Intensity:
Fold change:
Significance:
-
C’ GFP library in SD

nucleus:cytosol19.29 -
N' NOP1pr-GFP in SD

cytosol,punctate137.807 -
N' TEF2pr-mCherry in SD
cytosol80.8178 -
N' NATIVEpr-GFP in SD

cytosol20.604 -
N' TEF2pr-VC and Cyto-VN in SD

cytosol30.3065 -
C’ GFP library in SD+DTT

nucleus.cytosol17.110.88No -
C’ GFP library in SD+H2O2

nucleus.cytosol21.251.1No -
C’ GFP library in Starvation Media

nucleus,cytosol27.461.42No -
C’ GFP library on the background of Pup2-DaMP

nucleus:cytosol -
C’ GFP library on the background of CCT mutant

nucleus:cytosol19.84361.0278No
